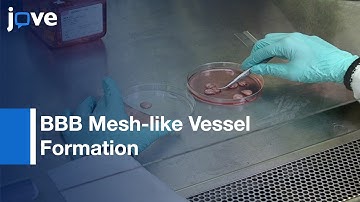

⬇ DOWNLOAD NOW
Kalau muncul iklan pop-up, tutup lalu klik tombol kembali
Download lagu Advanced in vitro models: beyond the standard simulation... BBB & CNS secara gratis hanya untuk keperluan promosi. Dukung artis favorit kamu dengan membeli musik original di iTunes atau platform resmi lainnya.
 Advanced in vitro models: Beyond the standard simulation... Ocular tissues
Advanced in vitro models: Beyond the standard simulation... Ocular tissues
 Advanced In Vitro Models - A Game Changer for Predictive Research
Advanced In Vitro Models - A Game Changer for Predictive Research
BBB Mesh-like Vessel Formation and Disruption: in vitro Assessment | Protocol Preview
BBB Mesh-like Vessel Formation and Disruption: in vitro Assessment | Protocol Preview
 MFEM Workshop 2025 | Real-Time Bayesian Inference at Extreme Scale
MFEM Workshop 2025 | Real-Time Bayesian Inference at Extreme Scale
 2nd In-Vitro 2D & 3D Neuronal Networks Summit - April 2022
2nd In-Vitro 2D & 3D Neuronal Networks Summit - April 2022
 Data-Informed Modeling to Accelerate the Improvement of Sustainable Tech | Micah Ziegler | BBISS
Data-Informed Modeling to Accelerate the Improvement of Sustainable Tech | Micah Ziegler | BBISS
 CIS Display™️: a fully in vitro platform for enhancing small-format discovery
CIS Display™️: a fully in vitro platform for enhancing small-format discovery
 Current Perspectives and New Directions Using the BCOP Assay: Applications in the Regulatory Arena
Current Perspectives and New Directions Using the BCOP Assay: Applications in the Regulatory Arena